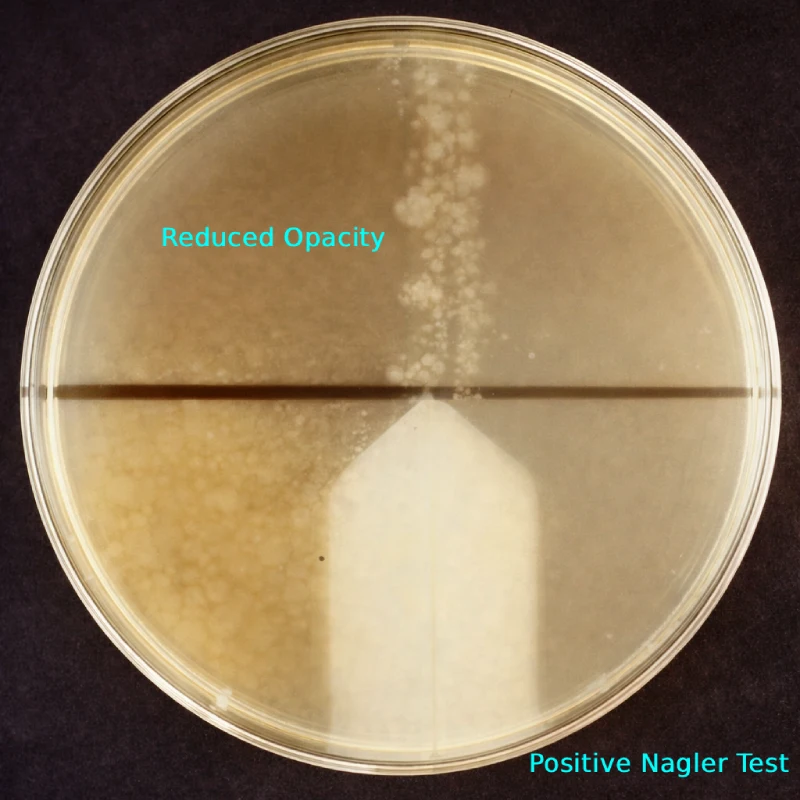
Nagler Reaction Test: Principle, Procedure & Interpretation

Clinicalsci.info provides practical, expert-guided content on clinical laboratory techniques, diagnostic workflows, and molecular biology procedures, helping students and professionals strengthen their laboratory skills and understanding.
Latest Posts
-
Strongyloides stercoralis: Principles, Procedures, and Clinical Significance
Strongyloides stercoralis, commonly known as the threadworm, is a soil-transmitted intestinal nematode capable of causing chronic and potentially life-threatening infections. While less prevalent than other intestinal nematodes, it remains a significant global health concern, particularly in tropical and subtropical regions of Asia, Latin America, and Africa. Estimates suggest that 30–100
-
Nagler Reaction Test: Principle, Procedure & Interpretation
The Nagler reaction, also known as the Nagler test, is a classical yet clinically significant phenotypic laboratory test used for the identification and confirmation of Clostridium perfringens based on its ability to produce lecithinase C (alpha toxin). The test relies on the neutralization of lecithinase activity by a specific antitoxin,
-
Serum Phosphate Test: Principle, diagnostic procedure & clinical significance
Serum inorganic phosphate, or serum phosphate, is a crucial electrolyte involved in phosphate homeostasis. It plays vital roles in bone mineralization, ATP energy metabolism, nucleic acid synthesis, cell signaling, and oxygen delivery in red blood cells via 2,3-diphosphoglycerate (2,3-DPG). About 85% of total body phosphate is stored in the skeleton
-
Reticulocyte Count: Procedure, Significance & Interpretation
In the field of clinical hematology, the reticulocyte count stands as a pivotal diagnostic tool that offers invaluable insights into the bone marrow’s erythropoietic activity. Reticulocytes are immature red blood cells (RBCs) that represent the transitional stage between nucleated erythroid precursors in the bone marrow and mature erythrocytes in the
-
Leishmaniasis: Life cycle, pathogenesis and laboratory diagnosis
Introduction Leishmaniasis, a vector-borne disease caused by protozoan parasites of the genus Leishmania, is transmitted through bites of infected female sandflies. As a neglected tropical disease, it affects millions globally, necessitating accurate laboratory diagnosis for effective management. The World Health Organization (WHO) estimates 12 million people are affected, with approximately